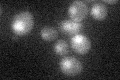
YOL125W
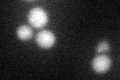
YOL125W
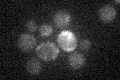
YOL125W

View description
2'-O-methyltransferase responsible for modification of tRNA at position 4; C-terminal domain has similarity to Rossmann-fold (RFM) superfamily of RNA methyltransferases
Localization:
Intensity:
Fold change:
Significance:
-
C’ GFP library in SD
nucleus21.15 -
N' NOP1pr-GFP in SD

nucleus101.003 -
N' TEF2pr-mCherry in SD

nucleus151.209 -
N' NATIVEpr-GFP in SD

nucleus25.6645 -
N' TEF2pr-VC and Cyto-VN in SD

#N/A0 -
C’ GFP library in SD+DTT
nucleus20.920.98No -
C’ GFP library in SD+H2O2

nucleus20.580.97No -
C’ GFP library in Starvation Media
nucleus15.970.75Yes -
C’ GFP library on the background of Pup2-DaMP

nucleus -
C’ GFP library on the background of CCT mutant

nucleus21.18961.00126No
